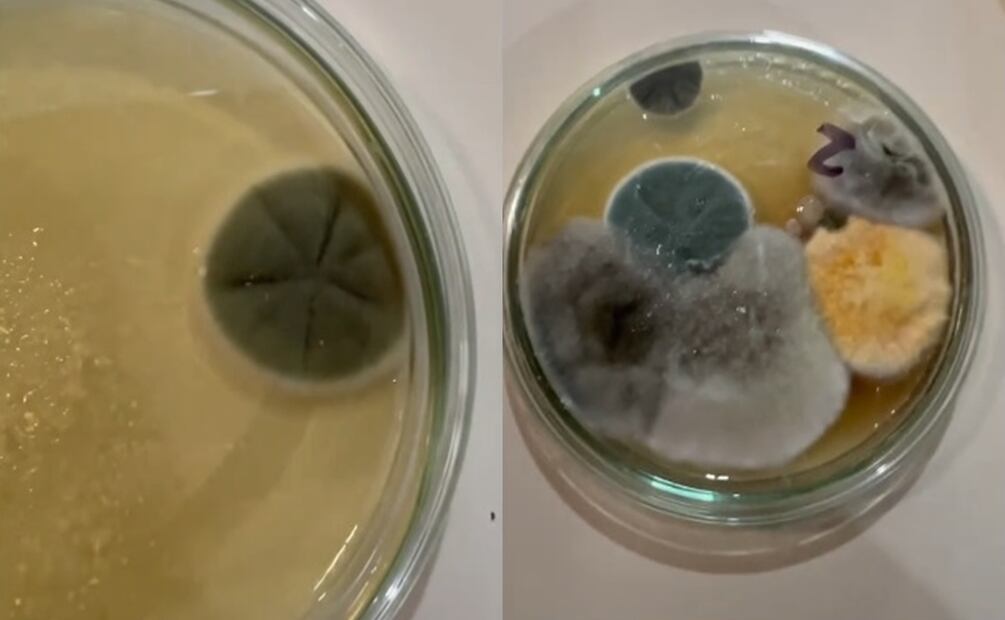
Microbios en el metro de la CDMX. Fuente: TikTok @preguntalealbiologo

Más Información
La Ciudad de México es una de las más importantes del continente americano y por la que circulan millones de personas, locales y turistas, cada año. Cuando se habla de esta ciudad se la relaciona directamente con el turismo y es por eso que en plataformas como TikTok se pueden encontrar diferentes videos que la muestran a diario.
Debido a la gran afluencia de personas los medios de transporte público son ampliamente utilizados en la Ciudad de México. Es por este motivo que una bióloga quiso realizar una investigación con el fin de hallar la presencia de microbios en uno de los medios más utilizados por locales y turistas.
Leer más: Cuáles son las 5 profesiones que serán más demandadas en 2025; descubre lo que dice la IA
Microbios en el metro de la CDMX
La investigación se centró en el metro de la Ciudad de México, por donde transitan miles y miles de personas a diario y en donde estas toman contacto con superficies como puertas, andenes, torniquetes, tubos y taquillas automáticas. Por lo tanto, la bióloga tomó muestras de estos y las colocó dentro de cajitas de Petri para luego cultivarlas en el medio Agar papa dextrosa.
Los resultados obtenidos fueron difundidos a través de un video que publicó en la cuenta de TikTok llamada @pregúntalealbiólogo. Los microbios encontrados, según explicó, eran principalmente hongos por lo que los internautas no tardaron en reaccionar con asombro ante lo revelado.
Aunque algunos usuarios de TikTok señalaron que era algo de esperar, otros hicieron referencia a la necesidad que una mejor higienización del metro de la Ciudad de México. Además, la bióloga remarcó que a pesar de la presencia de estos microbios esto no representaba un riesgo directo para la salud. Sin embargo, debe servir como alerta para mejorar nuestra higiene personal, antes y después de utilizar este medio de transporte tan requerido.
Únete a nuestro canal ¡EL UNIVERSAL ya está en Whatsapp!, desde tu dispositivo móvil entérate de las noticias más relevantes del día, artículos de opinión, entretenimiento, tendencias y más.
Noticias según tus intereses
[Publicidad]
[Publicidad]











